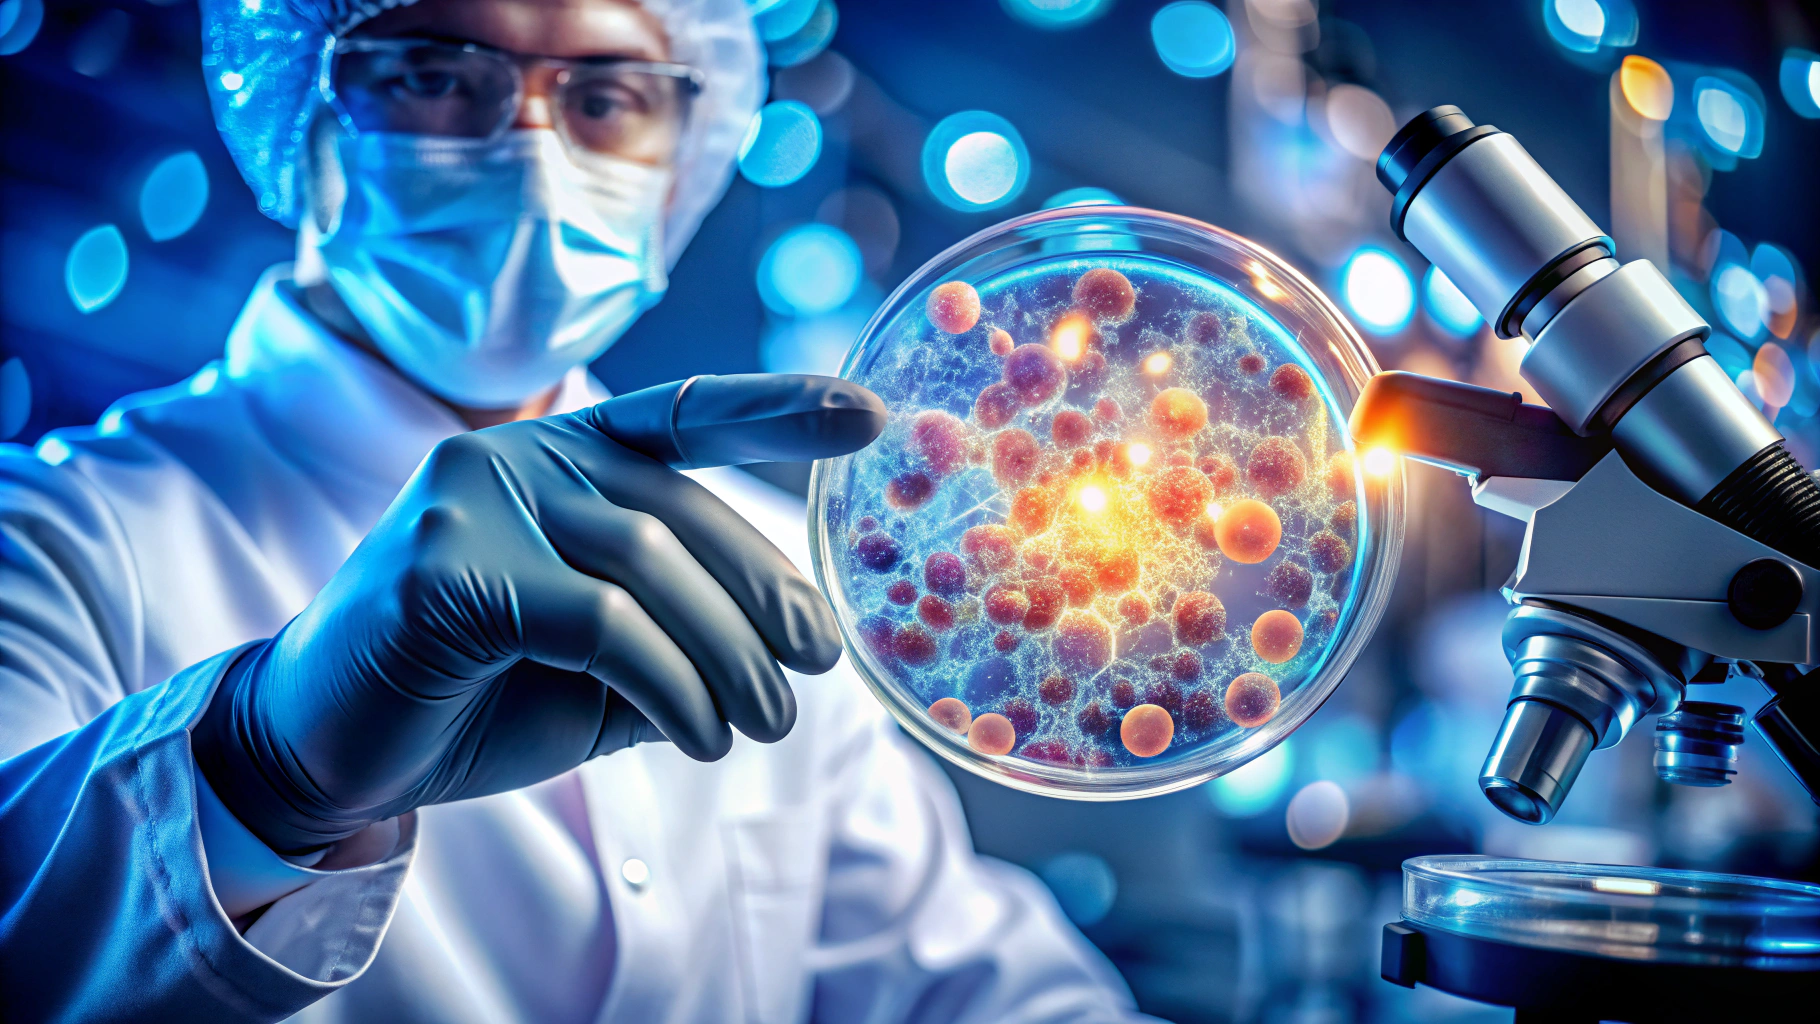

여러분의 탈모 고민, 2025년 최신 솔루션으로 해결하세요!

하루가 다르게 심해지는 머리카락 빠짐으로 밤잠 설치셨다면, 더 이상 스트레스받지 마세요. 2025년, 주목받는 다양한 탈모치료제 종류부터 혁신적인 최신 연구 동향까지, 전문가가 엄선한 핵심 정보를 알기 쉽게 정리했습니다. 이제 자신감을 되찾고 풍성한 머릿결을 되찾을 기회입니다! 이 글 하나로 탈모치료제에 대한 모든 것을 마스터하세요.
💊 탈모치료제, 크게 두 가지 주요 유형으로 나눌 수 있습니다

2025년 현재, 탈모치료제는 크게 안드로겐성 탈모와 원형탈모 치료제로 구분됩니다. 각 유형별 특징과 대표적인 약물, 그리고 최신 승인 정보를 자세히 살펴보겠습니다.
📈 안드로겐성 탈모 (남성형 탈모, AGA) 치료제: 효과 확실한 검증된 선택지
가장 흔하게 발생하는 안드로겐성 탈모 치료에는 오랜 기간 검증된 효과를 보여온 약물들이 있습니다. 남성형 탈모 진행을 억제하고 모발 건강을 되찾는 데 도움을 줍니다.
- 피나스테리드 (Finasteride): 남성형 탈모의 주범인 DHT(디하이드로테스토스테론) 생성을 억제하여 모발 빠짐을 효과적으로 막아줍니다. 탈모 초기 단계부터 꾸준히 복용 시 효과적입니다.
- 두타스테리드 (Dutasteride): 피나스테리드보다 강력한 DHT 억제 효과를 자랑합니다. 빠른 탈모 진행 억제를 원하시는 분들에게 고려될 수 있습니다.
- 미녹시딜 (Minoxidil): 두피의 혈류를 개선하고 모낭을 활성화하여 모발 성장기를 연장시키는 데 도움을 주는 국소 도포용 약물입니다. 남녀 모두에게 사용할 수 있으며, 경구용 약물과 함께 사용 시 시너지 효과를 기대할 수 있습니다.
🌟 원형탈모 치료제: 2025년, 획기적인 FDA 승인 신약의 등장!
자가면역 질환으로 인해 발생하는 원형탈모 치료 분야에서는 최근 획기적인 발전이 있었습니다. 바로 JAK 저해제 계열의 새로운 치료제들인데요, 이 약물들은 모낭을 공격하는 면역 반응을 선택적으로 억제하여 원형탈모 개선에 새로운 희망을 제시하고 있습니다.
- 바리시티닙 (올루미언트): FDA 승인을 받은 JAK 저해제로, 중등도에서 중증 원형탈모 환자의 모발 성장을 돕는 것으로 알려져 있습니다.
- 리틀레시티님 (리트풀로): 또 다른 JAK 저해제 계열 약물로, 원형탈모 치료에 있어 효과적인 대안으로 주목받고 있습니다.
2025년, 원형탈모로 고통받는 많은 분들께 이 최신 치료법들이 큰 도움이 될 것으로 기대됩니다.
🚀 미래를 바꿀 혁신적인 탈모 치료 연구 동향: 곧 현실이 될 가능성
현재 활발히 연구 중이거나 임상 단계에 있는 차세대 탈모 치료법들도 주목할 만합니다. 머지않아 우리가 만나볼 수 있을지도 모릅니다.
- RNA 간섭 (siRNA) 치료: 탈모를 유발하는 특정 유전자의 발현을 억제하는 첨단 유전자 치료법입니다. 모발 재생을 위한 근본적인 해결책을 제시할 잠재력이 큽니다.
- 모낭 줄기세포 활성화 치료: 저출력 레이저, 최신 줄기세포 치료 기술, 특수 모낭 주사 등 다양한 방법을 통해 모낭의 재생과 성장을 촉진하는 치료법들이 연구되고 있습니다.
- 냉각 치료 및 MTS(미세침 자극): 두피의 혈액 순환을 개선하고 모근의 건강을 증진하는 보조적인 치료 방법들도 긍정적인 연구 결과를 보여주고 있습니다.
특히 2025년 상용화를 목표로 하는 펠라지(Pelage)와 같은 혁신적인 모낭 재생 치료제는 임상 3상에서 매우 긍정적인 결과를 도출하며 큰 기대를 모으고 있습니다.
🤔 나에게 맞는 탈모치료제, 현명하게 선택하는 방법

탈모치료제 선택은 단순히 제품을 고르는 것을 넘어, 자신의 탈모 유형, 성별, 연령, 그리고 현재 탈모 진행 정도를 종합적으로 고려해야 합니다. 특히 여성이나 어린이는 호르몬 억제제 사용에 대한 제한이 있을 수 있으므로, 반드시 전문의와의 충분한 상담을 통해 가장 안전하고 효과적인 치료 계획을 수립하는 것이 중요합니다. 섣부른 자가 진단과 치료는 오히려 상태를 악화시킬 수 있습니다.
🌟 전문가 추천! 나에게 맞는 탈모치료제 선택 시 고려사항
- 정확한 탈모 유형 진단: 안드로겐성 탈모, 원형탈모, 휴지기 탈모 등 원인 파악이 최우선입니다.
- 성별 및 연령: 약물 선택의 폭과 주의사항이 달라질 수 있습니다.
- 탈모 진행 단계: 초기, 중기, 말기 등 진행 정도에 따라 치료 전략이 달라집니다.
- 기저 질환 및 복용 중인 약물: 상호작용 가능성을 반드시 확인해야 합니다.
- 원하는 치료 효과와 부작용 고려: 전문가와 충분히 상의하세요.
✅ 핵심 요약: 2025년 탈모치료제 종류별 특징
| 탈모 유형 | 주요 치료제 | 특징 및 고려사항 |
|---|---|---|
| 안드로겐성 탈모 | 피나스테리드, 두타스테리드 (경구용), 미녹시딜 (국소 도포용) | 남성형 탈모 진행 억제 및 모발 성장 촉진. 여성 및 어린이 사용 제한 확인 필수. |
| 원형탈모 | JAK 저해제 계열 (바리시티닙, 리틀레시티님 등) | 자가면역 반응 억제를 통한 모발 재생. 최신 승인 약물로 전문가 상담 중요. |
| 미래 치료법 | RNA 간섭, 줄기세포 활성화, 펠라지 등 | 연구 활발, 차세대 치료법으로 기대. |
오늘 소개해 드린 다양한 탈모치료제 정보가 여러분의 탈모 고민 해결에 실질적인 도움이 되기를 바랍니다. 꾸준한 관리와 올바른 치료법 선택으로, 잃어버렸던 자신감과 풍성하고 건강한 머릿결을 되찾으시길 응원합니다!
'건강' 카테고리의 다른 글
| 발기부전 치료제, 7가지 종류별 완벽 비교: 나에게 맞는 최적의 선택법 (2025년 최신 정보) (0) | 2025.11.05 |
|---|---|
| 발기부전 치료제 종류, 효과, 그리고 나에게 맞는 선택 가이드 (0) | 2025.11.05 |
| 발기부전 치료제 완벽 가이드: 7가지 핵심 정보와 최신 치료법 총정리 (2025년) (0) | 2025.11.04 |
| 아르기닌, 왜 중요할까요? 우리 몸의 놀라운 변화 (1) | 2025.11.02 |
| 놓치면 후회! 30분 투자로 1개월 만에 보톡스 부작용 확실히 잡는 주부 필살 비법 (2025 최신) (0) | 2025.11.01 |